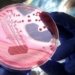
وەزارەتا چاندنێ شەش خال وەکو ڕێکارێن بەرهەنگاربوونا تایا خوینبەربوونێ بەلاڤکرن

وهزارهتا چاندنێ چهندين رێكارێن گرنگ بۆ رێگريكرنێ ژ بهلاڤبوونا تايا خوێن بهربوونێ دهركرينه و ژوان ژى داخواز كريه دياريا ئينانا ئاژهلى ب رهنگهكێ نه فهرمى بهێته قهدهغهكرن.
وهزارهتا چاندنێ ئاماژه ب وێ يهكێ كريه كو پێدڤيه بهرى ئاژهل بهێته سهرژێكرن و پشتى سهرژێكرن پشكنين بۆ بهێنه كرن و پێدڤيه ل جهێن فهرمى بهێنه سهرژێكرن و موهرا فهرمى يا ڤێرتهرنيێ پێڤه بيت و دڤێت ل كولان و سهر رێييان فرۆتنا ئاژهلى بهێته قهدهغهكرن.